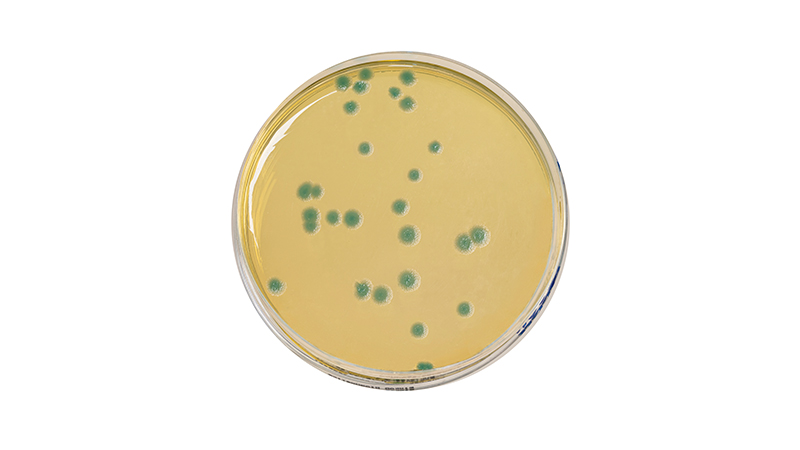
产品二.jpg
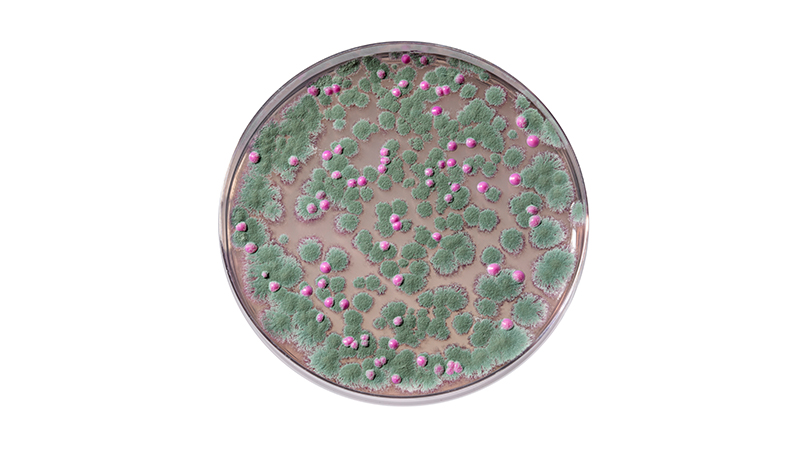
产品三.jpg

作为食品安全技术领域规模最大、人气最旺和最受欢迎的行业盛会之一,CBIFS第十八届食品安全技术论坛暨太平洋食安展将于2026年4月9日-10日在苏州举办。
博尔卡确认参展本次论坛,欢迎各位领导专家和客户朋友参观交流、合作洽谈!


上海博尔卡国际贸易有限公司
上海博尔卡国际贸易有限公司(Shanghai Biokar International Trade Co.Ltd)主营法国Biokar Diagnostics原装进口通用培养基、显色培养基、超快速显色培养基套装等产品。
Biokar Diagnostics公司隶属于Solabia集团,1972年成立,是一家专注于研究、生产、销售微生物实验室培养基、补充物、微生物快速检测产品以及鉴定试剂盒的全球性的高科技生物公司。Biokar公司在微生物学领域拥有50多年的经验,涉及的领域包括:农产品工业、化妆品行业、制药行业、水和环境、动物健康、研究机构和教育等,Biokar Diagnostics拥有超过数千种产品,在40多个国家设有分支机构,以其产品质量和创新解决方案赢得了国际声誉。公司的所有产品均遵循严格的标准,并通过ISO国际质量认证,部分产品通过AFNOR认证以及ISO的等效验证。
Solabia集团总部位于法国庞坦(接近巴黎),涉及生物技术、诊断学、化妆品(世界知名品牌香奈儿原料供货商)、保健品、药品等领域。集团拥有6个生产工厂、3个研发中心,五大类产品业务遍及全球。
电话:18930972629
地址:上海市奉贤区大叶公路5225号5幢5125室
网址:www.biokar-china.com

- 扫码关注公众号 -

Biokar 致病菌快速检测方案
按照NF EN ISO 16140标准验证,通过AFNOR认证的方法,最接近标准方法的快速检测方案。
IRIS SALMONELLA®沙门氏菌,37小时内进行阴性筛查,2分钟鉴定;
COMPASS® LISTERIA AGAR单增李斯特和李斯特菌属快速检测,46小时阴性筛查,6小时内确认单核细胞增生李斯特菌;
EASY STAPH® AGAR 金黄色葡萄球菌快速显色培养基,22小时计数凝固酶阳性葡萄球菌,直接读取有晕圈的菌落,无需确认。
CSD方法,37h同时快速检测沙门氏菌和克罗诺杆菌,2分钟鉴定沙门氏菌
人类食品,动物食品和环境样品
COMPASS® BACILLUS CEREUS AGAR
蜡样芽胞杆菌快速检测
按照NF EN ISO 16140标准验证,通过AFNOR认证的方法。
用于人类食品和动物饲料中蜡样芽胞杆菌的检测和计数。特征性绿色菌落和对次生菌群极好的抑制作用。仅在24小时内在一种平板上检测并计数,无需确认。
BACILLUS CEREUS培养基具有良好的营养细胞和孢子形式的恢复能力,使用的选择性成分可抑制大多数污染二级菌群,针对蜡样芽胞杆菌的特异性检测,包括卵磷脂酶产生微弱或阴性的菌株。
人类食品和动物饲料
SYMPHONY AGAR 霉菌和酵母快速检测
按照ISO 16140标准验证,通过AFNOR认证。
用于人类食品,动物食品和生产区域的环境样品中霉菌和酵母的计数,通过膜过滤处理也可以用于检测水质样品。
SYMPHONY琼脂的专业设计,可以优化霉菌和酵母的快速生产,确保抑制大多数污染细菌,霉菌和酵母菌落清晰可见。
仅需54小时可计数,无需确认。2022年被纳入雀巢全球推荐方法.
人类食品,动物食品和生产区域的环境样品

博尔卡测试片
微生物测试片为即用型培养检测体系,将样品直接加入测试片指定区域内,微生物利用营养组分生长繁殖,生长时产生的代谢产物与显色剂发生化学反应,从而使形成的微生物菌落着色,以此实现菌落的快速判读。相对传统方法,省去了制备培养基的时间、同时节省培养箱空间、携带户外操作方便。流程更简单,结果更快,更易读取,节省培养箱空间。
所有食品安全检测实验室

致病菌PCR试剂盒/动物源性试剂盒/转基因产品
生物分子诊断类试剂盒,使用简单,经过多行业客户验证,确保特异性及灵敏度,可实现快速鉴定。
动物源性试剂盒:鸡鸭鹅猪牛山羊绵羊狐狸貂鱼马等
致病菌试剂盒:金葡菌、沙门氏菌、金葡-沙门氏菌双重 、单增李斯特、克罗诺杆菌等
转基因试剂盒:CP4-EPSPS、Lectin、NOS、CaMV35S等
所有食品安全检测实验室

BIOCIAR涂抹棒/涂抹海绵产品
涂抹棒是一套能帮助您建立稳定、高效、系统的环境监控涂抹产品。
涂抹棒表面由纤维棉签构成,从而避免了普通棉花对细菌生长的抑制作用和蛋白的残留。涂抹棒在出厂前经过辐照灭菌消毒。内含的缓冲液为 BPW 或磷酸盐缓冲液或生理盐水,有助于微生物的修复和生长。
涂抹海绵是不含杀菌剂的纤维素海绵,附着在塑料手柄上,并在无菌袋中供应。长手柄使它更容易进入排水管、管道和设备 周围,主要用于大面积表面取样和难以到达区域。
所有食品安全检测实验室




